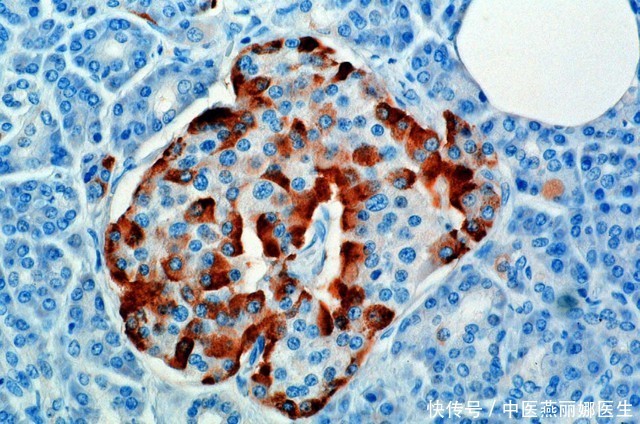

友情提示
本站部分转载文章,皆来自互联网,仅供参考及分享,并不用于任何商业用途;版权归原作者所有,如涉及作品内容、版权和其他问题,请与本网联系,我们将在第一时间删除内容!
联系邮箱:1042463605@qq.com
花生,是糖尿病的“加速器”?中医:保护胰岛,可牢记3吃、3不吃
69
0
相关文章
最新文章
标签云
饮食习惯
胰岛素抵抗
膳食纤维
健康
胆固醇
病毒感染
糖尿病
2型糖尿病
胰岛素
胰岛功能
脂肪含量
血糖
血糖控制
血管
反式脂肪酸
维生素e
总胆固醇
超声检查
肝脏
脂肪肝
预防脂肪肝
血脂异常
李明
银耳
锻炼
心血管疾病
血管堵塞
健康生活方式
冠心病
血管内皮
高血压
血管狭窄
含糖饮料
血液循环
慢性疾病
糖尿病患者
饮食
疾病
力量训练
一日三餐
睡眠质量
肌肉
体重
优质蛋白
蛋白质
调味料
高血压患者
炎症
神经细胞
腹型肥胖
武汉大学
中南医院
内分泌科
白糖
核桃
老郭
糖化血红蛋白
空腹血糖
早餐
老年人
同型半胱氨酸
维生素b12
mega
海鱼
二甲双胍
医保
降糖药
心理健康
热爱运动
热量
减肥
糖尿病人
并发症
血糖监测
视网膜病变
糖尿病并发症
复旦大学
维生素b6
维生素b2
维生素b
维生素b1
神经损伤
阿尔茨海默病
红薯
夏枯草
张伟
油炸食品
联合治疗
大蒜
肝硬化
转氨酶
骑自行车
肥胖
南瓜子
黑米
可溶性膳食纤维
糙米
睡眠时间
小米粥
燕麦片
他汀类
脂蛋白
医学标准
动脉粥样硬化
中疾控
自杀率
癌症患者
抑郁症患者
症状
治疗
新冠
2019冠状病毒病
医生
胰岛
饮品
内分泌
1型糖尿病
肝病
肝癌
其他
空腹
march
血糖值
成瘾
酒精
纳曲酮
植入者
戒酒芯片
细胞
科学
线粒体
science
泻药
麻药
麻醉药
上海市
肾脏
肾病
血液
芋头
高血脂
高胆固醇血症
西药
中药
西医
癌症
肺癌
吸烟
胃癌
中国
华科大
面包
面食
张医生
不良习惯
心脏
心肌梗死
心脑血管疾病
强身健体
植物油
不饱和脂肪酸
动物油
中国居民膳食指南
猪油
胡萝卜
便秘
肠道
西兰花
抗氧化物
菠菜
急性心肌梗死
心肌梗塞
心肌缺血
旅游
婆婆
哈佛大学
低密度脂蛋白
内分泌平衡
健康长寿
维生素k
学生时代
绿叶蔬菜
食用油
三高
维生素c
橙子
豌豆
脂肪
童童
吴迪
吴旋
罗瑾
妇产科
林巧稚
南京照相馆
山西
结婚
领养
心衰
新的生活
黑龙江省
心脏衰竭
美国
餐桌
营养学
慢性病
纪录片
了不起的食物
绝经
月经
更年期
排异
仙女病
红斑狼疮
红斑性狼疮
世界肝炎日
糖尿病足
神经病变
糖尿病肾病
营养物质
牙周病
口腔
糖尿病酮症酸中毒
胃黏膜
高脂血症
肠胃疾病
猪肝
土豆
湖北省
玉米油
垃圾食品
奶茶
皮肤瘙痒
全球气候变暖
南瓜
三阴交
穴位
中医
乳酸
肌肉痉挛
心脑血管
果糖
尿毒症
胆红素
app
体脂率
严浩翔
芹菜
中国文化
洋葱
健康食品
前列腺癌
山药
痛风
茄子
第一滴血
神经末梢
苦瓜
感染性疾病
中风
剧烈运动
酱牛肉
痛风患者
香港
张曦雯
天涯侠医
陈豪演员
院士
教授
北京
阮少平
总顾问
阳气
寒邪
病根
夏季养生
短剧
张力
现代
医学
名不虚传
北大
毕业
正骨
纯爱
恋恋
偶剧
追剧热潮
爱你韩国电视剧
奶粉
母乳
米汤
婴幼儿
张玄化
创业
留学
爱情
人生
沈惜凡
针灸
爱你
偶像剧
现偶剧
尴尬症
陈皮
穿搭
徐若晗
张凌赫
现代装
爱你王心凌专辑
草药
药膳
何苏叶
推拿
追剧
爱情剧
古装戏
治癌
李时珍
日本
外科
汉方
汉医
治愈
失眠
女经理
甜妹
江苏台
医德
宣扬
抗癌
儿科
药理
相信爱情
爱情故事
方剂
中药方
手术
囊肿
针刺
秘方
王晓
药王谷
抗癌中心
权健
股票
减税
体检
快递
业务量
天气
中国姑娘
奥运冠军
药用价值
白茅根
清热解毒
围城
卵子
三亚
外国游客
中医药
俄罗斯
黑木耳
红枣
绿茶
鸡蛋